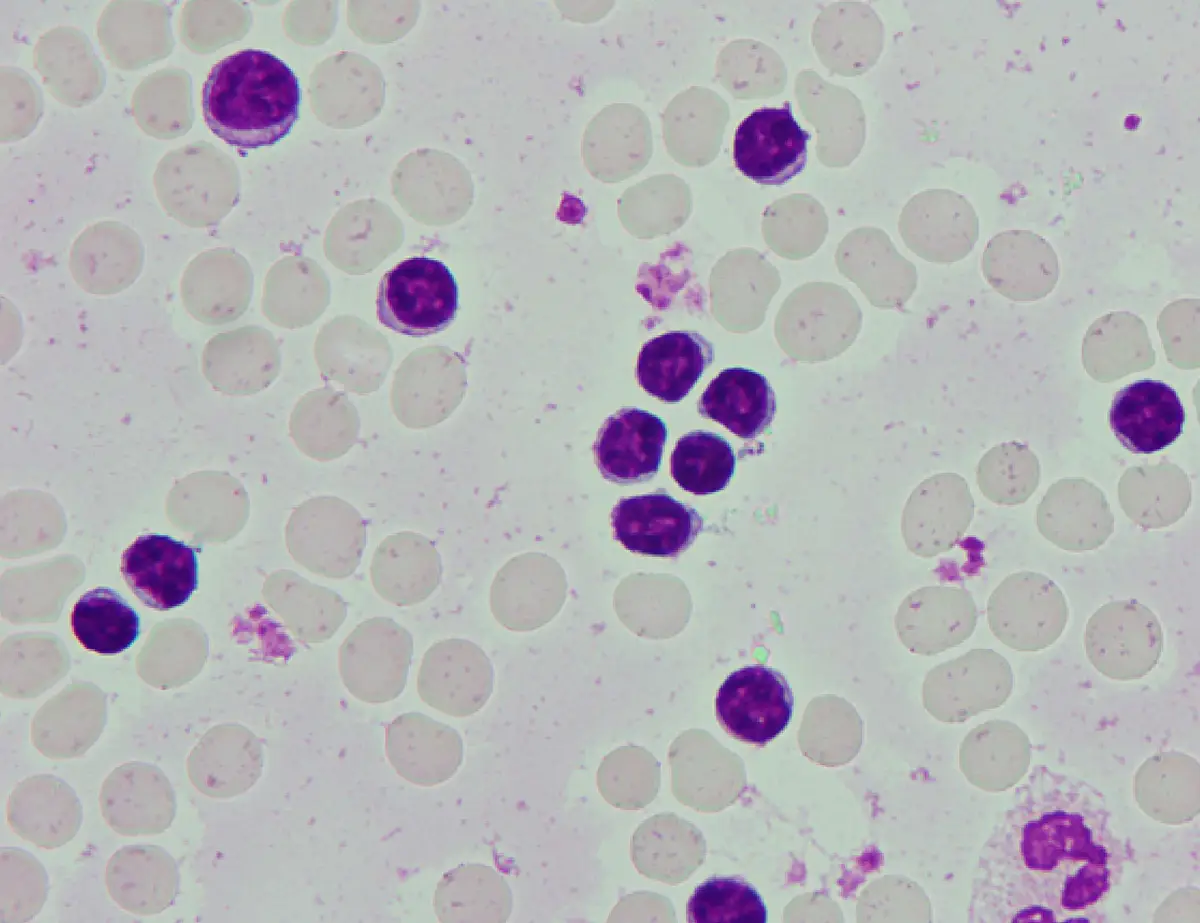
圖片

108年:醫學三(1)
⼀位 65 歲男性,其⾎液數據顯⽰,⽩⾎球⾼達 160,000/μL ,⾎紅素 12.7 g/dL ,⾎⼩板是 165,000/μL ,⽩⾎球分類顯⽰ segmented neutrophil 14% ,lymphocyte 80.3% ,無不成熟⾎球。其⾎液抹片之細胞顯⽰如下圖。這些淋巴球表達 CD19 、CD5 、dim CD20 、CD23 、dim kappa light chain restriction 。⽽ CD10 與CD34 均陰性。以下關於這位病⼈最可能的疾病之診斷與治療,何者錯誤?
A典型的周邊⾎液抹片常出現 basket cells 或smudge cells
B⼤多數的病⼈需要接受⾼劑量化學治療與異體造⾎幹細胞移植,以得到⻑期的存活
C有些病⼈會合併有 autoimmune thrombocytopenia 或autoimmune hemolytic anemia
D此類病⼈⼀開始通常無明顯與此病相關的症狀,⽽是偶然抽⾎檢驗⾎球數據時才發現此病
詳細解析
本題觀念:
本題考慮一位 65 歲男性,白血球高達 160,000/μL,淋巴球占 80.3%,無不成熟血球,且流式細胞儀顯示 CD19⁺、CD5⁺、dim CD20⁺、CD23⁺、dim kappa light chain restriction,CD10⁻、CD34⁻。此為慢性淋巴性白血病(chronic lymphocytic leukemia, CLL)的典型表現。本題為「何者錯誤」的反向題,需找出與 CLL 臨床事實不符的敘述。
影像分析:
周邊血液抹片(peripheral blood smear)以 Wright-Giemsa 染色呈現:
- 大量小淋巴球:視野中可見數量明顯增多的小至中型淋巴球,胞質稀少,核染色質濃縮呈「足球縫線」狀(mature-appearing lymphocytes),核仁不明顯——此為 CLL 細胞典型形態。
- Smudge cells(basket cells):抹片中可見多處紫色無定形殘骸狀細胞,即塗抹細胞(smudge cells),又稱 basket cells。此因 CLL 淋巴球細胞質脆弱(fragile cytoskeleton),在製作抹片時受壓力而破裂,是 CLL 的病理特徵性所見。
- 紅血球:形態正常,呈正色素性(normochromic)、正球性(normocyt
...(解析預覽)...
![醫師[2] - 白血病、淋巴瘤及骨髓疾病 - AI 圖文解析預覽](/_next/image?url=https%3A%2F%2Fbgvxfcrmbdvefjhuvrmt.supabase.co%2Fstorage%2Fv1%2Fobject%2Fpublic%2Fvisual-explanations%2F683%2F45447_t17254s5b.webp&w=3840&q=75)
升級 VIP 解鎖圖文解析